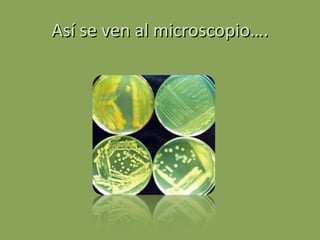
Así se ven al microscopio….

Las células procariotas son las más primitivas y se encuentran en organismos unicelulares del reino monera como bacterias y cianobacterias. Carecen de núcleo y otros orgánulos, pero algunas tienen cápsula. Se reproducen asexualmente por fisión binaria y pueden ser aerobias, anaerobias o facultativas. Algunas bacterias son patógenas pero otras son beneficiosas para la producción de alimentos y vitaminas.